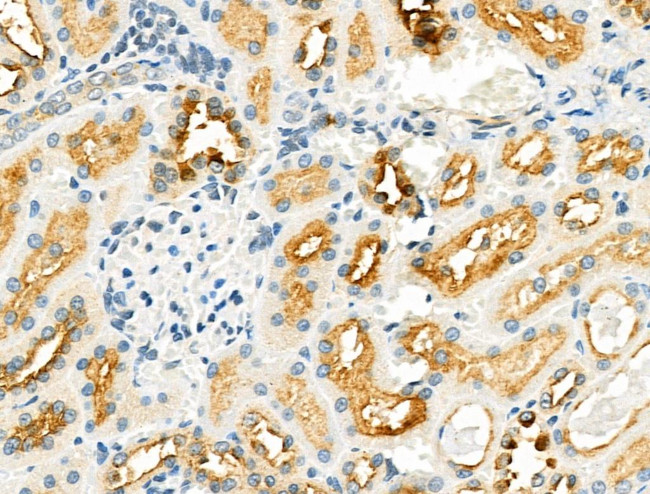
ZP1 Antibody in Immunohistochemistry (Paraffin) (IHC (P))

Search
Invitrogen
ZP1 Polyclonal Antibody
{{$productOrderCtrl.translations['antibody.pdp.commerceCard.promotion.promotions']}}
{{$productOrderCtrl.translations['antibody.pdp.commerceCard.promotion.viewpromo']}}
{{$productOrderCtrl.translations['antibody.pdp.commerceCard.promotion.promocode']}}: {{promo.promoCode}} {{promo.promoTitle}} {{promo.promoDescription}}. {{$productOrderCtrl.translations['antibody.pdp.commerceCard.promotion.learnmore']}}
图: 1 / 2
ZP1 Antibody (PA5-101973) in IHC (P)


产品信息
PA5-101973
种属反应
已发表种属
宿主/亚型
分类
类型
抗原
偶联物
形式
浓度
规格
纯化类型
保存液
内含物
保存条件
运输条件
RRID
产品详细信息
Antibody detects endogenous levels of total ZP1.
靶标信息
The mammalian zona pellucida, which mediates species-specific sperm binding, induction of the acrosome reaction and prevents post-fertilization polyspermy, is composed of three to four glycoproteins, ZP1, ZP2, ZP3, and ZP4. ZP1 ensures the structural integrity of the zona pellucida.
仅用于科研。不用于诊断过程。未经明确授权不得转售。
生物信息学
蛋白别名: epididymis luminal protein 163; mgc87693; Zona pellucida glycoprotein 1; zona pellucida glycoprotein 1 (sperm receptor); Zona pellucida sperm-binding protein 1; Zp-1; zp1 protein
基因别名: HEL163; OOMD; OOMD1; OZEMA1; ZP1; ZPB1
UniProt ID: (Human) P60852, (Rat) O54766, (Mouse) Q62005
Entrez Gene ID: (Human) 22917, (Rat) 85271, (Mouse) 22786